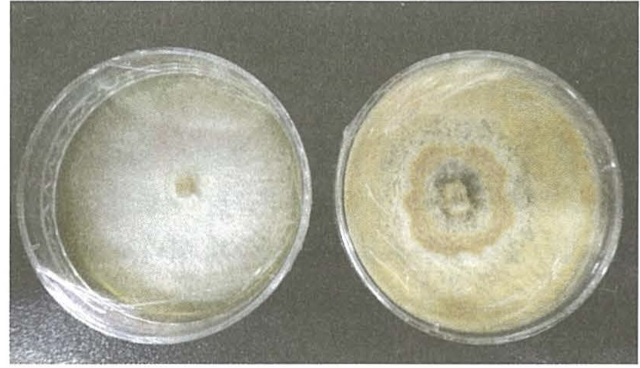

식물 진단법의 종류: 육안관찰, 배양적진단, 생리화학적 진단, 해부학적 진단, 현미경적 진단, 면혁학적(혈청학적 진단), 분자 생물학적 진단
가. 육안관찰: 맨눈으로 관찰

나. 배양적 진단: 조사를 하다 보니 죽었다 그럼 번거로움을 없애기 위해 인위적으로 병원체들을 증식시키는 것이 배양이다.
1. 여과지 습실처리법
병징이나 표징이 나타나지 않을 때 사용
수입종자 검역시 가장 많이 사용한다
멸균된 페트리접시에 여과지를 2 장 넣고 멸균 수로- 여과를 시킨다는 말은 걸러낸다는 의미다. 멸균수로 적시는데 이것은 무균의 물을 의미함. 거기에 병든 식물체를 올려두고. 그럼 3-7일 뒤에 물과 혼합이 되는데 물들은 가라앉고 미생물 증식이 일어남 그것을 관찰하는 것- 다시 이야기해서 먹을 것을 그대로 가져와서 키우는 방법

2. 영양배지법
잎이나 종자를 가져왔는데 증식을 안해서 그래서 어쩔 수 없이 인공적으로 영을 공급 (치아염소산나트륨으로 표면소독 물한천배지(우뭇가사리 세포막성분, 영양배지에 배양)
*배양이 되는 미생물에만 반드시 적용됨
다. 생리화학적 진단
식물이 병에 걸렸을 때 변하는 화학적성질을 조사 - 시약이나 각종 화학물질을 가지고 식물을 진단하는 방법
| 황산구리법 | 바이러스(감자모자이크 바리얼스 병)-- 자주색 |
| 그람염색법- 세균 | 세균에 의한 대강의 진단법 그람양성균, 그람음성균 세균의 세포벽 성분- 펩티도글리칸 thick 그람양성균 만약 얇으면 그람 음성균 크리스탈 바이올렛 시약( 자주색 염색) → 그다음 세정 (에탄올) 만약 양성균은 크리스탈 바이올렛 안 씻겨짐, 하지만 음성균은 씻겨짐—> 사프라닌 (빨간색 염색) 수목을 가해하는 대부분의 성분은 그람 음성균 |
| Biolog에 의한 탄소원 이용여부 검정법 | 세균에게 만약 00 종의 음식을 주면 아마 자기가 먹을것을 선호하는 것을 보고 검증하는 방법 |
라. 해부학적 진단
육안으로 안을 볼 수없을 때 조직 내부를 조사 (현미경) 현미경적 진단 아님 (주의)
방법 줄기를 잘라 물에 담금 (담궈서 물에 퍼지면 물 조사)
자실체 조직을 잘라 동정
해부현미경 (빛-가시광선-색깔이보임) < 광학현미경(가시광선) (한계가 있음, 빛의 회절현상)
< 투과전자현미경(전자로 그림을 그림)
마. 현미경적 진단
바 면역학적(혈청학적 진단)
| 진단법 | 육안관찰 가능: | 균총(세균 집합체), 자실체(곰팡이), 봉합체(바이러스) |
| 현미경적 진단 | 해부현미경: | 곰팡이, 선충 |
| 광학현미경 | 곰팡이, 선충, 세균, 바이러스 봉입체 | |
| 투과전자현미경(TEM) | 세균의 부속사, 바이러스 입자, 파이토플라스마 | |
| 주사전자현미경(SEM) | 곰팡이, 세균의 표면정보 | |
| 형광현미경 | 파이토플라스마(형광물질을 갖고있음) | |
| 면역학적 (혈청학적) 진단 거의모든 생명체가능(바이러스도) |
병든식물에서 분리한 병원균을 항혈청을 만든후 병원체와 반응시켜 조사 | -응집과 침강반응 -면역효소항체법(엘리사법) -면역확산법(한천이중확산법) -ISEM법, dot-blot assay, dip-stick법 |
면역학적 진단 (계속)
피에서 혈구 응고물질을 빼면 혈청이라 부르는데 항이라는 말은 항체가 들어가 있어서 그렇다.
식물의 즙액이라든지 항체랑 항원이 만나서 항원항체 복합체를 형성했다 싶으면 항체가 형성되었다.
응집침강반응
항원항체가 모이면 응집 침강(물에 가라앉음) 그런 부분을 관찰하면서 병을 진단하는 방법(정량적인방법)
면역효소항체법, 엘리사법: 항원항체가 작기 때문에 찾기 어렵다. 불빛이 나는 꼬리를 붙이자. (발광효소)
면역확산법(한천이중확산법) 한천에 구멍을 뚫고 구멍마다 진단하고 싶은 즙액을 넣으면 조금 시간이 지나면 선이 발생(침강선)
사. 분자생물학적 진단
DNA 이용
DNA 추출- PCR 증폭하여 분석하여 DNA 데이터베이스에 등록된 것과 비교 동정
- 병원체 별 동정부위
1. 세균, 파이토플라스마: 16 rRNA 유전자 분석 (16 침강계수 rRNA : 리보솜 RNA)
2. 곰팡이: ITS (internal Rranscribed Spacer)
3. t식물: 엽록체의 matK, rbcL
4. 바이러스: 프라이머 분석




진단법 요약
1. 바이러스
- 내,외부 병징관찰 : 모자이크, 오갈병(쭈글쭈글)
-검정식물(지표식물)에 의한 생물학적 진단
-면역학적(혈청학적)진단 항혈청 만들어 집액 만들어서 바이러스도 자기혼자 물질대사 못하지만 감염상태일땐 면역학적(혈청학적( 작용
-PCR (분자생물학적진단) 바이러스도 유전자를 가지고 있기에 유전자를 가지고 있는 생물은 가능하다
2. 파이토플라스마
- 톨루이딘블루(toluidine blue)의 조직 염색에 의한 광학 현미경 기법- 어느정도 형태 확인 가능
-공초점 레이저 현미경 (confocal laser microscoy) - 어느 정도 빛의 확산을 막는 발달된 현미경
- DAPI 등의 형광염색소를 사용한 형광현미경 기법
- 아날린블루(aniline blue)를 이용한 형광현미경 기법
- 딘즈(Dienses) 염색약을 이용한 광학 현미경 기법
- DNA probes, RFLP probes 및 16s RNA 유전자 분석 (세균도 이것을 가지고 분석함)
3. 세균 (세균은 증식이 이분법으로 굉장이 빠르므로 배양적진단이 불필요하다)
- 해부학적 진단/ 면역학적(혈청학적) 진단 (잘라서 물어 담궈서 함)
-분자생물학적 진단 (16 SrRNA)
-생리화학적 진단
가. 그람염색법(세포벽 펩티도글리칸 이용) , Biolog
나. 세포막의 지방산 조성 분석 (굉장히 많이 쓴다. 세부적인 정보를 알기 위해 세포막에 있는 지방산이 있는데
길이 2 단결함 유무 위치, Cis, Trans 결합유무에 따라 어떤 세균인지 동정할 수 있다.
4. 곰팡이
- 배양적진단/ 해부학적 진단 (곰팡이 감염 줄기를 잘라서 물에 담궈 진단)
- 포착목(미끼) 이용진단(리지나뿌리썩음병, 아밀라리아뿌리썩음병)
- 진핵세포이면서 물질대사 하기때문에 면역학적 진단 가능하다.
5. 선충
외부병징에 의한 진단(위축, 시들음, 황화현상)
- 베르만(Baermann)깔때기법을 이용한 광학 현미경 관찰( 베르만 깔때기는 선충을 걸러주는 역할
-선충의 비중을 이용한 방법
- 여러가지 크기의 체(sieve)를 이용하는 방법
현미경 관측 가능범위
육안확인가능: 균총(세균집합에), 자실체(곰팡이 집합체), 봉합체(바이러스)
해부현미경: 곰팡이, 선충
광학현미경: 곰팡이, 선충, 세균
투과전자현미경(TEM): 세균의부속사, 바이러스 입자, 파이토플라스마
주사전자현미경(SEM): 곰팡이, 세균 표면정보
형광전자현미경: 파이토 플라스마
'수목병리학' 카테고리의 다른 글
| 수목 병원성별 진단방법(바이러스, 파이토플라스마, 세균, 곰팡이, 선충) (0) | 2025.01.28 |
|---|---|
| 파이토 플라스마에 의한 수목 병해 (0) | 2025.01.26 |
| 세균에 의한 수목병 기억해야 할 것들 (0) | 2025.01.26 |
| 수목병의 발생 (0) | 2025.01.25 |
| 우리나라 수목병의 역사 및 연구 (0) | 2025.01.23 |